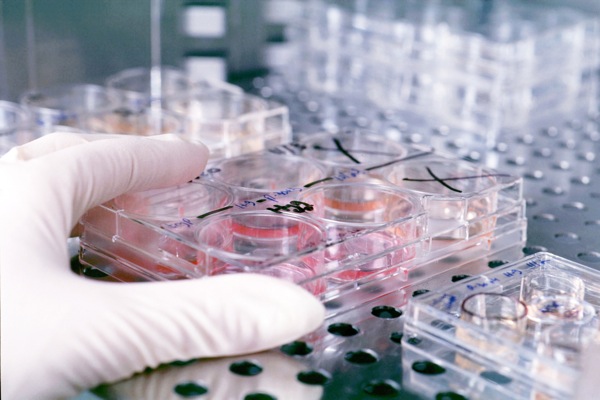
Θερίζει η πανώλη στη Μαδαγασκάρη-40 νεκροί

Θερίζει η πανώλη στη Μαδαγασκάρη-40 νεκροί
Ο Παγκόσμιος Οργανισμός Υγείας ανακοίνωσε την εμφάνιση της πανώλης στη Μαδαγασκάρη και προειδοποίησε για τον κίνδυνο της γρήγορης εξάπλωσης της επιδημίας στην πρωτεύουσα Ανταναναρίβο.
Ο ΠΟΥ ανέφερε χθες το βράδυ σε ανακοίνωσή του ότι ενημερώθηκε στις 4 Νοεμβρίου από τις υγειονομικές αρχές της Μαδαγασκάρης για την εξάπλωση της ασθένειας, το πρώτο θανατηφόρο κρούσμα της οποίας καταγράφηκε σε ένα χωριό την 31η Αυγούστου.
Σύμφωνα με τον ΠΟΥ, στις 16 Νοεμβρίου είχαν καταγραφεί 119 κρούσματα και 40 θάνατοι. Από αυτά, τα δύο κρούσματα με ένα θάνατο στην Ανταναναρίβο.
«Στην πρωτεύουσα υπάρχει τώρα κίνδυνος γρήγορης εξάπλωσης της ασθένειας εξαιτίας της μεγάλης πυκνότητας του πληθυσμού στην πόλη και των ελλείψεων του συστήματος υγείας», σημειώνει ο οργανισμός, χαρακτηρίζοντας περίπλοκη την κατάσταση εξαιτίας της αντίστασης των παρασίτων στο εντομοκτόνο που χρησιμοποιείται για την εξόντωσή τους.
Η πανώλη μεταδίδεται μέσω των ψύλλων που βρίσκονται στο τρίχωμα των ποντικιών και άλλων τρωκτικών. Στους ανθρώπους εμφανίζεται αρχικά στη βουβωνική χώρα με διόγκωση των λεμφαδένων.Αν το βακτήριο φτάσει στους πνεύμονες προκαλεί πνευμονία και τότε μπορεί να μεταδοθεί από άνθρωπο σε άνθρωποι μέσω του βήχα.
Η βουβωνική μορφή της πανώλης θεραπεύεται με αντιβιοτικά, όμως η πνευμονική της εξέλιξη είναι μια από τις πιο θανατηφόρες μεταδιδόμενες ασθένειες που μπορεί να αποβεί μοιραία για τον άνθρωπο σε μόλις 24 ώρες.